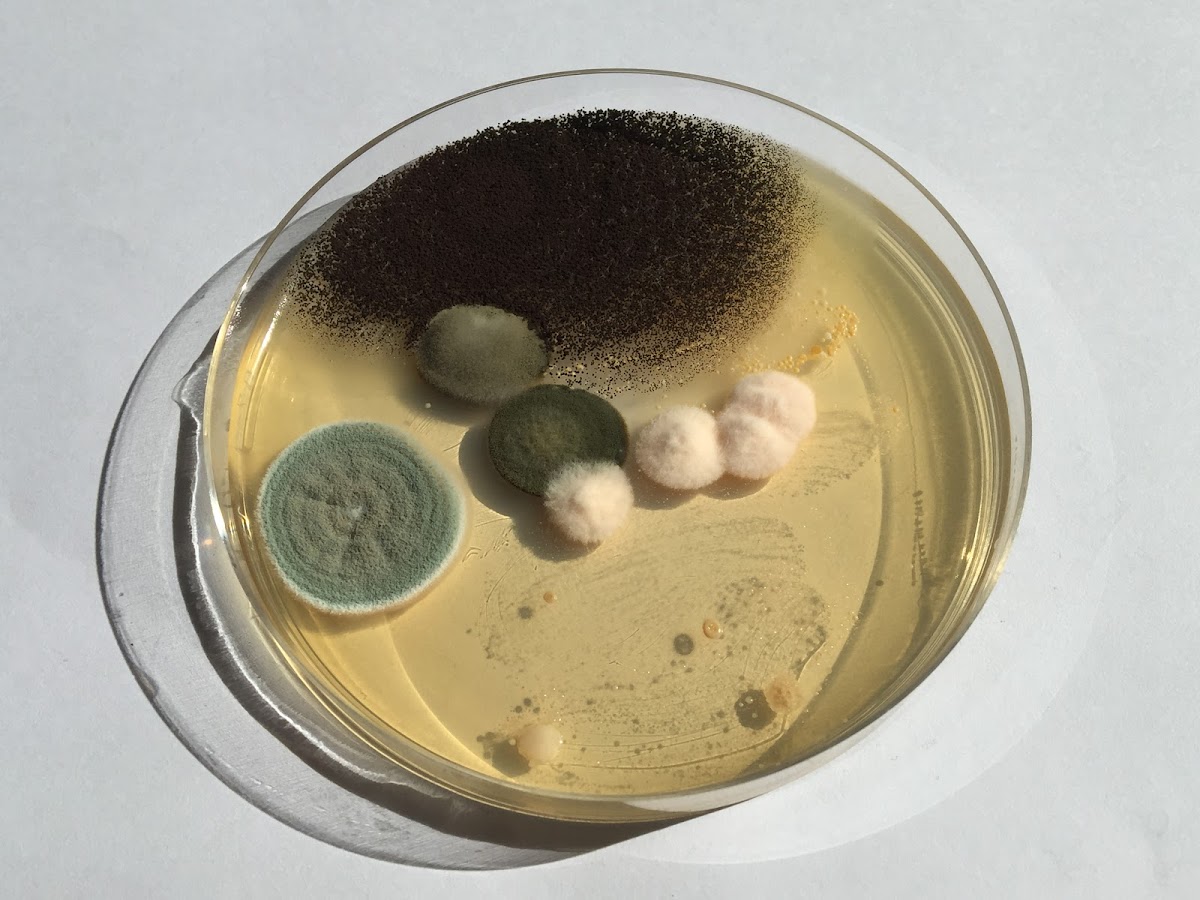

Sie sind der Inhaber von hydrolytics?
Stellen Sie jetzt einen Antrag, um dieses Unternehmensprofil zu verwalten. Nach erfolgreicher Verifizierung können Sie:
- Ihre Kontaktdaten aktualisieren
- Fotos und Beschreibungen hinzufügen
- Auf Kundenanfragen reagieren
- Bewertungen beantworten
- Unternehmen löschen
Sie müssen angemeldet sein, um einen Antrag zu stellen.
Vielen Dank! Ihr Antrag wurde erfolgreich übermittelt. Wir prüfen Ihre Angaben und melden uns in Kürze per E-Mail.